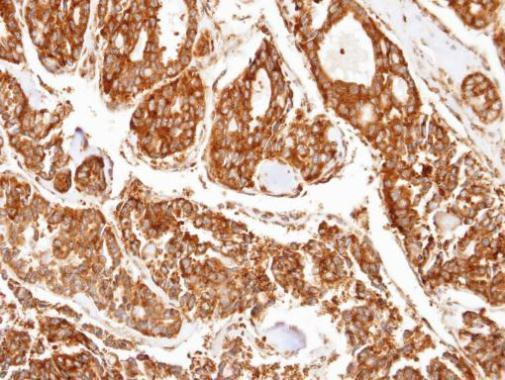
PPP2R5D Antibody in Immunohistochemistry (Paraffin) (IHC (P))

Search
Invitrogen
PPP2R5D Polyclonal Antibody
{{$productOrderCtrl.translations['antibody.pdp.commerceCard.promotion.promotions']}}
{{$productOrderCtrl.translations['antibody.pdp.commerceCard.promotion.viewpromo']}}
{{$productOrderCtrl.translations['antibody.pdp.commerceCard.promotion.promocode']}}: {{promo.promoCode}} {{promo.promoTitle}} {{promo.promoDescription}}. {{$productOrderCtrl.translations['antibody.pdp.commerceCard.promotion.learnmore']}}
产品信息
PA5-28445
宿主/亚型
分类
类型
抗原
偶联物
形式
浓度
规格
保存条件
运输条件
RRID
产品详细信息
Recommended positive controls: HeLa, A549, IMR32, HCT116, PPP2R5D shRNA-transfected HeLa.
Predicted reactivity: Mouse (100%), Pig (100%), Rabbit (100%), Bovine (100%).
Store product as a concentrated solution. Centrifuge briefly prior to opening the vial.
靶标信息
Zinc-finger proteins contain DNA-binding domains and have a wide variety of functions, most of which encompass some form of transcriptional activation or repression. ZNF265 (Zinc finger protein 265), also known as ZRANB2 (Zinc finger Ran-binding domain-containing protein 2), ZIS, ZIS1 or ZIS2, is a 330 amino acid protein that belongs to the ZRANB2 family. Localized to the nucleus, ZNF265 functions as a splicing factor that is responsible for alternatively splicing Tra-2 beta (transformer-2 beta) transcripts and is thought to interfere with constitutive 5'-splice selection. ZNF265 contains two RanBP2-type zinc fingers through which it conveys its RNA-binding activity. Two isoforms, designated ZIS-1 and ZIS-2, are expressed due to alternative splicing events. Upon DNA damage, ZIS-2 may be phosphorylated by ATM or ATR.
⚠WARNING: This product can expose you to chemicals including mercury, which is known to the State of California to cause birth defects or other reproductive harm. For more information go to www.P65Warnings.ca.gov.
仅用于科研。不用于诊断过程。未经明确授权不得转售。